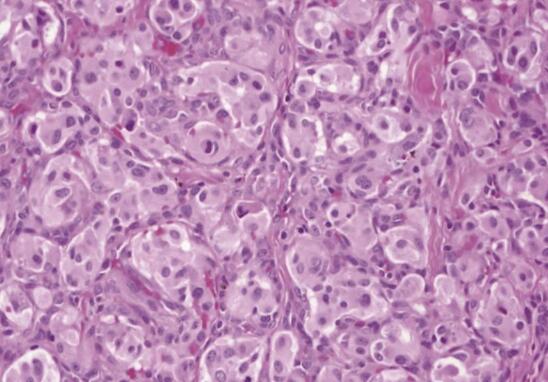

50岁女性,因反复头昏3年就诊。曾当地医院诊断为继发性高血压、可疑嗜铬细胞瘤/副神经节瘤,治疗后头昏症状缓解,但血压仍波动于150~170/90~106mmHg。该患者怎么了?如何治疗?
患者女性,50岁。因反复头昏3年就诊。3年前患者无明显诱因出现头昏,伴心慌、乏力、出汗及面色苍白,无头痛、恶心、呕吐,无晕厥及黑矇,无视物模糊,无胸闷、胸痛,无气紧,就诊于当地诊所。测血压180/130mmHg,给予药物静滴治疗(具体不详),头昏症状缓解,血压降至120~130/80~90mmHg。随后到当地医院就诊,完善相关检查后,发现腹膜后肿瘤(约2cm),诊断为高血压、腹膜后肿瘤。曾先后服用利血平、硝苯地平等药物治疗(具体不详)。血压波动在120~200/70~130mmHg,血压升高时头昏、心慌、乏力。1天前患者无明显诱因再发头昏、心慌、乏力,蹲下站起时发作晕厥1次,意识恢复后仍感头昏、乏力、四肢麻木,再次就诊于当地医院,急诊测血压176/106mmHg,诊断为继发性高血压、可疑嗜铬细胞瘤/副神经节瘤。给予苯磺酸左氨氯地平2.5mg/d、琥珀酸美托洛尔缓释片47.5mg/d、特拉唑嗪片2mg/d治疗后患者头昏症状有所缓解,血压波动于150~170/90~106mmHg。为进一步治疗转入上级医院。
患者自患病以来,神志清,精神可,饮食可,睡眠差,大小便正常。
【既往史、个人史、家族史】
无特殊。
【月经生育史】
孕1产1,顺产。14岁初潮,每28~30天来一次月经,每次持续5天,经量正常,49岁绝经。
【体格检查】
T 36.5℃,P 112次/min,R 20次/min,BP 198/108mmHg,BMI 22kg/m2。神志清楚,急性病容,多汗,皮肤巩膜无黄染,全身浅表淋巴结未扪及肿大,甲状腺未扪及肿大。颈静脉正常。心界正常,心律齐,二尖瓣区可闻及柔和2/6级吹风样杂音。胸廓未见异常,双肺叩诊呈清音,双肺呼吸音清,未闻及干湿啰音。腹部外形正常,全腹软,无压痛及反跳痛,未触及包块。腹部(颈部、胸部)未闻及血管杂音。肝、脾肋下未触及。脾肋下未触及。双肾未触及。双下肢无水肿。
【辅助检查】
血常规、尿常规、粪便常规未见明显异常。尿白蛋白/肌酐1.5mg/g。
心电图(图1):窦性心动过速,左室高电压,ST-T改变。

图1 心电图示窦性心动过速,左室高电压,ST-T改变
血儿茶酚胺(血压186/100mmHg):血浆肾上腺素187.13pg/ml、血浆去甲肾上腺素2 200.27pg/ml、血多巴胺114.83pg/ml。甲状腺功能大致正常。皮质醇(8:00)41.962nmol/L、皮质醇(16:00)6.955nmol/L、皮质醇(24:00)5.435noml/L。ACTH(8:00)23.588pg/dl、ACTH(16:00)14.330pg/dl、ACTH(24:00)10.545pg/dl。
【初步诊断】
1. 高血压原因待查,可疑嗜铬细胞瘤/副神经节瘤。
2. 高血压3级、很高危。
3. 可疑高血压心脏病?
【诊治经过】
入院后进一步完善相关检查:
1.儿茶酚胺激素水平
尿儿茶酚胺:去甲肾上腺素853.92μg/24h,肾上腺素36.87μg/24h,多巴胺 226.52μg/24h。
血儿茶酚胺:去甲肾上腺素7 370ng/L,肾上腺素106ng/L。
血浆甲氧基肾上腺素类物质(三项):3-甲氧基酪胺<0.08nmol/L,甲氧基肾上腺素0.36nmol/L,甲氧基去甲肾上腺素16.91nmol/L。
2.肾素-血管紧张素-醛固酮激素水平
醛固酮-肾素活性-血管紧张素Ⅱ测定:血浆肾素活性(卧位)0.95ng/(ml·h);血管紧张素Ⅱ(卧位)54.79ng/L,醛固酮(卧位)17.95ng/dl,血浆醛固酮/肾素浓度比值(ARR)(卧位)18.89[(ng·dl-1):(ng·ml-1·h-1)]。
3.促肾上腺皮质激素(adrenocorticotropic hormone,ACTH)、皮质醇节律和水平
皮质醇:皮质醇(8~10点)127.1nmol/L,皮质醇(16~18点)121.1nmol/L,皮质醇(24点)173.40nmol/L。复查(2019-4-1):皮质醇(8~10点)479.30nmol/L,皮质醇(16~18点)480.30nmol/L,皮质醇(24点)473.00nmol/L;ACTH正常。1mg过夜地塞米松抑制试验:次晨皮质醇41.962nmol/L。
4.影像、超声检查
双肾及肾动脉彩超:腹主动脉左侧实性占位(建议行超声造影或其他检查明确性质)。
全腹增强CT(图2):腹主动脉前方肿块,肿块截面大小约7.7cm×4.1cm,部分包绕腹主动脉、双侧肾动脉近段、左肾静脉,左肾上腺外支局部分界欠清,考虑副神经节瘤的可能性大。

图2 全腹部增强CT检查
超声心动图:LV 44mm,LA 37mm×45mm×59mm,RV 20mm,RA 40mm,IVS 13mm,LVPW 11mm,EF 62%;左房稍大,主动脉稍增宽,室间隔增厚,三尖瓣反流(轻度),左室收缩功能测值正常。
5.血压测量
四肢血压:左上肢204/127mmHg,左下肢206/125mmHg,右上肢205/129mmHg,右下肢209/127mmHg;
卧立位血压:212/133mmHg(立位 1min),218/133mmHg(立位 2min),220/137mmHg(立位 3min)。
结合血、尿儿茶酚胺及血浆甲氧基肾上腺素类物质水平、影像学检查,符合嗜铬细胞瘤/副神经节瘤定性定位诊断标准。入院后给予1mg/ml酚妥拉明注射液静脉注射2~5ml(酚妥拉明(1ml:10mg)50mg加入0.9%氯化钠注射液45ml配制为1mg/ml的酚妥拉明注射液50ml),再予以1.5ml/h微泵泵入控制血压,根据血压调整泵入剂量。后续口服酚苄明片,起始小剂量10mg/次,2次/d,依据血压情况逐渐增加剂量至10mg/次,4次/d,由于患者心率增快明显,联合使用美托洛尔缓释片(71.25mg/次,2次/d)。调整血压并请血管外科会诊后手术治疗。术前予0.9%氯化钠注射液2 000ml/d,持续2周补液扩容。
经多科讨论,该患者转入血管外科手术治疗,术中见后腹膜一7cm×4cm不规则包块位于左肾静脉下方,腹主动脉和下腔静脉正前方,往上推及左肾静脉,肿瘤血供丰富,腹主动脉前可见数根直径2~3mm肿瘤滋养血管。剖解包块标本可见花岗岩样纹理,合并有囊内出血。病理示(图3):均匀分布的多边形嗜铬/主细胞巢,周围有支持细胞和良好的血管网。术后患者住院期间血压波动于110~120/70~80mmHg。
图3 手术切除组织标本病理
2~4周后门诊复查血儿茶酚胺(catecholamine,CA)、血浆甲氧基肾上腺素类物质水平正常。患者出院后长期电话随访,间断到当地社区监测血压及家庭自测血压,血压水平在130/70mmHg左右。患者术后随访血压正常,故未再给予降压药物治疗。
【修正诊断】
继发性高血压:嗜铬细胞瘤/副神经节瘤。
【讨论】
1.什么是嗜铬细胞瘤,什么是副神经节瘤
嗜铬细胞瘤和副神经节瘤是分别起源于肾上腺髓质或肾上腺外交感神经链的肿瘤。主要合成和分泌大量儿茶酚胺,包括去甲肾上腺素、肾上腺素及多巴胺,引起患者血压升高等一系列临床症候群,并造成心、脑、肾等严重并发症。
2.嗜铬细胞瘤/副神经节瘤有哪些临床表现
主要表现为高儿茶酚胺(catecholamine,CA)分泌所致的高血压及其并发症。由于肿瘤持续或阵发分泌不同比例的肾上腺素和去甲肾上腺素,可表现为阵发或持续性血压升高,或在持续性血压升高基础上阵发加重,头痛、心悸、多汗是嗜铬细胞瘤/副神经节瘤高血压发作时最常见的三联症。此患者表现为持续血压升高,阵发加重,同时有头昏、心慌,符合嗜铬细胞瘤/副神经节瘤的临床表现。高CA血症通过升高血压造成心室肌肥厚,还可以直接损伤心肌,导致心肌纤维化、心肌缺血,急性冠脉综合征和心律失常。这种由高CA血症引起的心脏损害称为儿茶酚胺性心肌病(CA-CM),儿茶酚胺性心肌病导致的心律失常、心力衰竭及心肌梗死是嗜铬细胞瘤/副神经节瘤患者手术前的最常见死因。该患者心电图及常规心脏超声提示左室肥厚,心电图有ST-T改变,需警惕。患者予口服α受体阻滞剂后心率增快,给予β受体阻滞剂控制心率,需注意用药后可能出现心脏失代偿及心力衰竭加重等情况。手术切除肿瘤后,大部分儿茶酚胺性心肌病患者的心律失常及心肌缺血消失,心电图及心功能恢复正常,心室肥厚也能逆转,但心肌梗死病灶会长期存在。
3.嗜铬细胞瘤/副神经节瘤的诊断依据
嗜铬细胞瘤/副神经节瘤诊断主要依据临床症状、定性诊断、影像解剖和功能定位诊断。嗜铬细胞瘤/副神经节瘤的临床表现已在问题2中进行讨论。本部分主要介绍定性诊断、影像解剖和功能定位诊断。激素及代谢产物的测定是定性诊断的主要方法,包括测定血和尿去甲肾上腺素(norepinephrine,NE)、肾上腺素(epinephrine,E)、多巴胺(dopamine,DA)及其中间代谢产物甲氧基肾上腺素(metanephrine,MN)、甲氧基肾上腺素类物质(MNs)能明显提高嗜铬细胞瘤/副神经节瘤的诊断敏感性及降低假阴性率,推荐有条件的医疗单位作为首选。定性诊断后再进行肿瘤的影像学检查定位,常用方法包括计算机断层扫描(computed tomography,CT),磁共振成像(magnetic resonance imaging,MRI),CT对胸、腹和盆腔组织有很好的空间分辨率,并可发现肺部转移病灶。MRI对颅底和颈部副神经节瘤定位诊断具有更高的敏感性。嗜铬细胞瘤/副神经节瘤的功能影像学检查包括间碘苄胍显像(metaiodobenzylguanidine scintigraphy,MIBG scintigraphy),生长抑素受体显像及18F-氟代脱氧葡萄糖正电子发射断层成像。对于有转移或转移风险的患者,间碘苄胍显像结果可以评估患者是否适合131I-MIBG治疗。生长抑素受体显像可用于筛查恶性副神经节瘤的转移病灶。18F-氟代脱氧葡萄糖正电子发射断层成像是肾上腺外的交感性副神经节瘤、多发性、恶性嗜铬细胞瘤/副神经节瘤的首选定位诊断方法。
4.如何对嗜铬细胞瘤/副神经节瘤患者进行术前准备
除头颈部和分泌多巴胺的嗜铬细胞瘤/副神经节瘤外,均应给予α受体阻滞剂[酚苄明:起始剂量5~10mg/次,2次/d,维持剂量1mg/(kg·d);多沙唑嗪:2mg/d,维持剂量32mg/d]做术前准备。如血压仍未控制满意,可加用钙通道阻滞剂;用α受体阻滞剂后出现心动过速,则加用β受体阻滞剂。但是绝对不能在未服用α受体阻滞剂之前使用β受体阻滞剂,因为先服用β受体阻滞剂可导致急性肺水肿和左心衰竭。服药至少2~4周。此外,术前患者应摄入高钠饮食和增加液体摄入量,以增加血容量,防止肿瘤切除后发生严重低血压,可输注0.9%氯化钠注射液进行补液,每天计划补液2 000ml,连续补液2周,补液同时密切监测心率、血压。术前药物准备充分的标准:①患者血压控制正常或基本正常,无明显体位性低血压;②血容量恢复:红细胞比容降低,体重增加,肢端皮肤温暖,微循环改善;③高代谢症候群及糖代谢异常得到改善;④术前药物准备时间存在个体差异,一般至少为2~4周,对较难控制的高血压并伴有严重并发症的患者,应根据患者病情相应延长术前准备时间。
5.嗜铬细胞瘤导致的高血压能否根治
良性嗜铬细胞瘤/副神经节瘤导致的高血压切除肿瘤后血压恢复正常的患者约70%,血压未能恢复正常的患者,可能合并原发性高血压或肾性高血压。恶性嗜铬细胞瘤/副神经节瘤无法手术或术后复发的患者,高血压将持续存在,需要给予降压药物控制血压。
6.什么是嗜铬细胞瘤危象,应该怎么处理
因术前或术中挤压、触碰肿瘤或使用某些药物(如糖皮质激素、β受体阻滞剂、甲氧氯普胺、麻醉药)以及创伤、其他手术应激等使嗜铬细胞瘤/副神经节瘤突然释放大量CA,导致患者出现血压急剧升高或高、低血压反复交替发作合并严重的心、脑、肾器官功能障碍的现象。嗜铬细胞瘤危象的发生率约为10%,可导致患者发生休克,最终因呼吸、循环衰竭死亡。嗜铬细胞瘤危象是需要紧急处理的急、危重症。立即静脉泵入α受体阻滞剂,从小剂量开始并严密监测血压、心率变化,根据患者对药物的降压反应,逐渐增加和调整剂量;如高、低血压反复交替发作,除静脉泵入α受体阻滞剂外,还需另建一条静脉通道进行容量补液、监测血流动力学指标并纠正低容量休克。嗜铬细胞瘤危象死亡率较高,需多学科合作,密切监测并对患者进行个体化治疗。
7.哪些患者应该考虑进行嗜铬细胞瘤/副神经节瘤的筛查
临床应对以下患者进行嗜铬细胞瘤/副神经节瘤筛查:①有嗜铬细胞瘤/副神经节瘤症状,尤其是阵发性血压升高患者;②使用多巴胺D2受体拮抗剂,拟交感神经类、阿片类、去甲肾上腺素或5-羟色胺再摄取抑制剂、单胺氧化酶抑制剂等药物可诱发嗜铬细胞瘤/副神经节瘤症状发作的患者;③肾上腺偶发瘤伴或不伴高血压的患者;④有嗜铬细胞瘤/副神经节瘤家族史或嗜铬细胞瘤/副神经节瘤相关的遗传综合征家族史患者;⑤有既往史的嗜铬细胞瘤/副神经节瘤患者。
8.哪些基因变异可以导致遗传性嗜铬细胞瘤/副神经节瘤(详见表1)。
表1遗传性嗜铬细胞瘤/副神经节瘤的致病基因

PCC:嗜铬细胞瘤;AD:常染色体显性遗传;PT:父系遗传;HM:血管母细胞瘤;RCC:肾透明细胞癌;PL:胰腺病变;MTC:甲状腺髓样癌;HP:甲状旁腺功能亢进症;NF:神经纤维瘤病;GIST:胃肠道间质瘤;PA:垂体瘤;UM:子宫肌瘤;NE:去甲肾上腺素;E:肾上腺素;SDHAF2:琥珀酸脱氢酶复合物组装因子2;-:未见;±:极少见;+:较少见
9.临床诊治嗜铬细胞瘤/副神经节瘤的流程(流程详见图4)。

图4 2016年《嗜铬细胞瘤和副神经节瘤诊断治疗的专家共识》推荐的诊治流程
MN:甲氧基肾上腺素;NMN:甲氧基去甲肾上腺素;18F-FDG-PET/CT:18F-氟代脱氧葡萄糖正电子发射断层成像
10.怎样对嗜铬细胞瘤/副神经节瘤术后患者进行随访
术后患者应终身随访,有基因(如SDHB基因)突变的患者,恶性嗜铬细胞瘤/副神经节瘤的可能性大,复发和转移可能性高,需要每3~6个月随访1次,无基因突变的嗜铬细胞瘤/副神经节瘤患者可以1年随访1次。随访时需注意:①患者的症状、体征、血/尿儿茶酚胺水平;②注意双侧肾上腺部分切除或孤立性肾上腺行单侧肾上腺部分切除的患者可能存在继发性肾上腺皮质功能减退的风险;③术后2~4周应复查CA或血浆甲氧基肾上腺素类物质水平以明确是否成功切除肿瘤。
【小结】
该患者诊断继发性高血压、嗜铬细胞瘤/副神经节瘤。诊断依据:中年女性,病程长,血压阵发性升高伴头昏、心慌。实验室检查发现血、尿儿茶酚胺、儿茶酚胺中间代谢产物水平升高,皮质醇分泌节律、水平及RAAS系统激素水平正常(该患者予口服α受体阻滞剂后心率增快,加用β受体阻滞剂控制心率,可能对RAAS激素水平造成影响),影像学检查发现腹主动脉前方肿块,部分包绕腹主动脉、双侧肾动脉近段、左肾静脉,左肾上腺外支局部分界欠清,查体四肢血压差值在正常范围,腹部无血管杂音。入院后的相关检查排除了皮质醇增多症、原发性醛固酮增多症、甲状腺功能亢进及肾实质/血管性高血压。再结合临床表现、影像学和生化检查,明确诊断为嗜铬细胞瘤/副神经节瘤。嗜铬细胞瘤/副神经节瘤临床表现多样,对典型的阵发性血压升高,头痛、心悸、多汗的患者应进行激素水平测定,按专家共识推荐流程进行定位及定性筛查。同时对不具有典型临床表现的嗜铬细胞瘤/副神经节瘤患者也应该提高警惕。嗜铬细胞瘤/副神经节瘤不同基因类型可导致不同的遗传综合征,临床在针对嗜铬细胞瘤/副神经节瘤诊断和治疗的同时应该考虑遗传综合征的其他系统表现。另外,应注意嗜铬细胞瘤/副神经节瘤与其他继发性高血压病因的鉴别诊断,在处理嗜铬细胞瘤/副神经节瘤患者时通常需要多学科协作。
通过此病例学习,我们应该掌握嗜铬细胞瘤/副神经节瘤的规范化诊治流程、典型临床表现和鉴别诊断。熟悉嗜铬细胞瘤/副神经节瘤的不典型临床表现,同时了解具有嗜铬细胞瘤/副神经节瘤特征的常见遗传综合征。
(荣溪 何霁云 李舍予)
参考文献
1. Lenders JWM, Quan-Yang D, Graeme E, et al. Pheochromocytoma and Paraganglioma: An Endocrine Society Clinical Practice Guideline [J]. Journal of Clinical Endocrinology&Metabolism, 2014, 99 (6): 1915-1942.
2. 中华医学会内分泌学分会肾上腺学组. 嗜铬细胞瘤和副神经节瘤诊断治疗的专家共识 [J]. 中华内分泌代谢杂志, 2016 (32): 181-187.
3. Shah MH, Goldner WS, Halfdanarson TR, et al. NCCN Guidelines Insights: Neuroendocrine and Adrenal Tumors, Version 2. 2018 [J]. J Natl Compr Canc. Netw, 2018, 16 (6): 693-702.
4. Plouin PF, Amar L, Dekkers OM, et al. European Society of Endocrinology Clinical Practice Guideline for long-term follow-up of patients operated on for a phaeochromocytoma or a paraganglioma [J]. European Journal of Endocrinology, 2016, 174 (5): G1-G10.
(环球医学编辑:余霞霞)
免责声明
版权所有©人民卫生出版社有限公司。 本内容由人民卫生出版社审定并提供,其观点并不反映优医迈或默沙东观点,此服务由优医迈与环球医学资讯授权共同提供。
如需转载,请前往用户反馈页面提交说明:https://www.uemeds.cn/personal/feedback
来源:《社区高血压病例精粹》
作者:陈晓平
页码:11
出版:人民卫生出版社





 Copyright © 2025 Merck & Co., Inc., Rahway, NJ, USA and its affiliates. All rights reserved.
Copyright © 2025 Merck & Co., Inc., Rahway, NJ, USA and its affiliates. All rights reserved.
